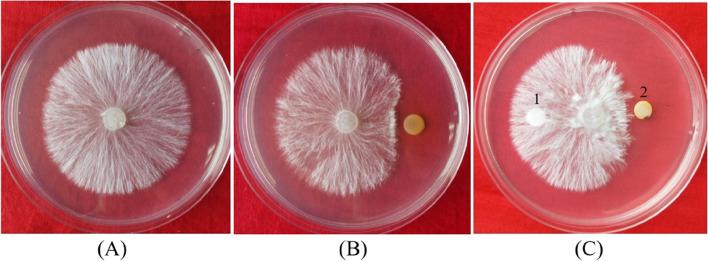

假单胞菌 zm-1 对花生茎腐病的生物防治特性及其作用机制。
Characteristics of biological control and mechanisms of Pseudomonas chlororaphis zm-1 against peanut stem rot.
机构信息
Institute of Microbial Engineering, Laboratory of Bioresource and Applied Microbiology, School of Life Sciences, Henan University, Kaifeng, 475004, China.
Engineering Research Center for Applied Microbiology of Henan Province, Kaifeng, 475004, China.
出版信息
BMC Microbiol. 2022 Jan 5;22(1):9. doi: 10.1186/s12866-021-02420-x.
BACKGROUND
Peanut stem rot is a serious plant disease that causes great economic losses. At present, there are no effective measures to prevent or control the occurrence of this plant disease. Biological control is one of the most promising plant disease control measures. In this study, Pseudomonas chlororaphis subsp. aurantiaca strain zm-1, a bacterial strain with potential biocontrol properties isolated by our team from the rhizosphere soil of Anemarrhena asphodeloides, was studied to control this plant disease.
METHODS
We prepared extracts of Pseudomonas chloroaphis zm-1 extracellular antibacterial compounds (PECEs), determined their antifungal activities by confrontation assay, and identified their components by UPLC-MS/MS. The gene knockout strains were constructed by homologous recombination, and the biocontrol efficacy of P. chlororaphis zm-1 and its mutant strains were evaluated by pot experiments under greenhouse conditions and plot experiments, respectively.
RESULTS
P. chlororaphis zm-1 could produce extracellular antifungal substances and inhibit the growth of Sclerotium rolfsii, the main pathogenic fungus causing peanut stem rot. The components of PECEs identified by UPLC-MS/MS showed that three kinds of phenazine compounds, i.e., 1-hydroxyphenazine, phenazine-1-carboxylic acid (PCA), and the core phenazine, were the principal components. In particular, 1-hydroxyphenazine produced by P. chlororaphis zm-1 showed antifungal activities against S. rolfsii, but 2-hydroxyphenazine did not. This is quite different with the previously reported. The extracellular compounds of two mutant strains, ΔphzH and ΔphzE, was analysed and showed that ΔphzE did not produce any phenazine compounds, and ΔphzH no longer produced 1-hydroxyphenazine but could still produce PCA and phenazine. Furthermore, the antagonistic ability of ΔphzH declined, and that of ΔphzE was almost completely abolished. According to the results of pot experiments under greenhouse conditions, the biocontrol efficacy of ΔphzH dramatically declined to 47.21% compared with that of wild-type P. chlororaphis zm-1 (75.63%). Moreover, ΔphzE almost completely lost its ability to inhibit S. rolfsii (its biocontrol efficacy was reduced to 6.19%). The results of the larger plot experiments were also consistent with these results.
CONCLUSIONS
P. chlororaphis zm-1 has the potential to prevent and control peanut stem rot disease. Phenazines produced and secreted by P. chlororaphis zm-1 play a key role in the control of peanut stem rot caused by S. rolfsii. These findings provide a new idea for the effective prevention and treatment of peanut stem rot.
背景
花生茎腐病是一种严重的植物病害,会造成巨大的经济损失。目前,还没有有效的预防或控制这种植物病害的措施。生物防治是最有前途的植物病害防治措施之一。在本研究中,我们研究了从知母根际土壤中分离出的具有潜在生防特性的细菌菌株假单胞菌属中橙色亚种 zm-1,以控制这种植物病害。
方法
我们制备了假单胞菌属 zm-1 细胞外抗菌化合物(PECEs)的提取物,通过对峙试验测定其抑菌活性,并通过 UPLC-MS/MS 鉴定其成分。通过同源重组构建基因敲除菌株,通过温室条件下的盆栽试验和田间试验分别评价假单胞菌属 zm-1 及其突变菌株的生防效果。
结果
假单胞菌属 zm-1 能产生细胞外抗真菌物质,抑制花生茎腐病主要病原菌立枯丝核菌的生长。UPLC-MS/MS 鉴定的 PECEs 成分表明,三种吩嗪类化合物,即 1-羟基吩嗪、吩嗪-1-羧酸(PCA)和核心吩嗪,是主要成分。特别是假单胞菌属 zm-1 产生的 1-羟基吩嗪对立枯丝核菌表现出抑菌活性,但 2-羟基吩嗪没有。这与之前的报道有很大不同。分析两个突变菌株ΔphzH 和 ΔphzE 的胞外化合物发现,ΔphzE 不产生任何吩嗪类化合物,而ΔphzH 不再产生 1-羟基吩嗪,但仍能产生 PCA 和吩嗪。此外,ΔphzH 的拮抗能力下降,而ΔphzE 的拮抗能力几乎完全丧失。根据温室盆栽试验的结果,与野生型假单胞菌属 zm-1(75.63%)相比,ΔphzH 的生防效果显著下降至 47.21%。此外,ΔphzE 几乎完全丧失了抑制立枯丝核菌的能力(其生防效果降低至 6.19%)。田间试验的结果也与这些结果一致。
结论
假单胞菌属 zm-1 具有防治花生茎腐病的潜力。假单胞菌属 zm-1 产生和分泌的吩嗪类化合物在防治立枯丝核菌引起的花生茎腐病中起关键作用。这些发现为有效防治花生茎腐病提供了新的思路。